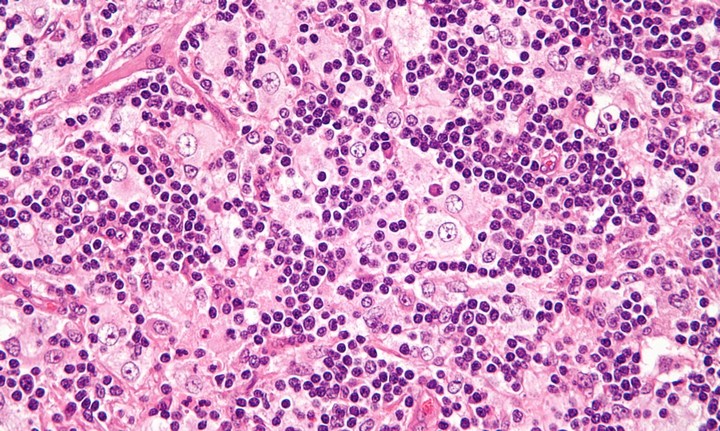
Фото Риск массовых заболеваний

10 радикальных последствий таяния льдов Антарктиды
Риск массовых заболеваний
Антарктический лед содержит микроорганизмы, которые были заморожены примерно 750 000 лет назад, задолго до появления человека. Если судить по истории, мы, вероятно, окажемся уязвимыми к болезням и патогенам, которые содержатся в этих микроорганизмах. Хотя эти микробы давно выработали иммунитет к патогенам, замерзшим под льдом, люди не смогут похвастаться такой защитой.
Некоторые ученые называют Антарктиду "кладовой генов", поскольку, вероятно, в этом хранилище содержатся и смертоносные заболевания. Представление о таких открытиях напоминает начало какого-то фильма ужасов или книги Тома Клэнси! Но последствия могут быть очень реальными. Биологи, как могли, пытались размораживать участки льда и изучать микроорганизмы внутри. Однако даже это оказалось сложной и опасной задачей. На самом деле, уже произошли несколько смертельных инцидентов.
В последние годы размороженные бактерии вызвали вспышки опасных заболеваний, таких как оспа, бубонная чума и сибирская язва. Именно последний патоген стал причиной смертоносной мини-пандемии в 2016 году. Наблюдая за этим разрушением на меньшем уровне, ученые уверены, что это не последний случай такого размораживания. Поэтому исследователи должны продолжать изучать возможные риски, связанные с размороженными бактериями и вирусами, чтобы предотвратить будущие вспышки заболеваний.
Однако по мере того как лед Земли тает, мы продолжаем подвергать себя большему риску, что давно замороженные бактерии будут вновь активированы. В одном случае ученые обнаружили доказательства существования восьмимиллионных бактерий, скрытых глубоко в ледяной шапке Антарктиды. Потенциальные неожиданные последствия, связанные с этими древними микроорганизмами, могут привести к возникновению совершенно нового — и опасного — мира. Как только лед начнет таять полностью, будет трудно остановить неизбежное распространение этих угроз.